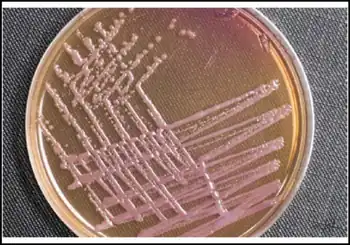

Burkholderia pseudomallei
| Burkholderia pseudomallei | |
|---|---|
| Burkholderia pseudomallei colonies on Ashdown's agar showing the characteristic cornflower head morphology | |
| Scientific classification | |
| Domain: | Bacteria |
| Kingdom: | Pseudomonadati |
| Phylum: | Pseudomonadota |
| Class: | Betaproteobacteria |
| Order: | Burkholderiales |
| Family: | Burkholderiaceae |
| Genus: | Burkholderia |
| Species: | B. pseudomallei
|
| Binomial name | |
| Burkholderia pseudomallei (Whitmore 1913)
Yabuuchi et al. 1993[1] | |
| Synonyms | |
|
Bacillus pseudomallei Whitmore 1913 | |
Burkholderia pseudomallei (also known as Pseudomonas pseudomallei) is a Gram-negative, bipolar, aerobic, motile rod-shaped bacterium.[2] It is a soil-dwelling bacterium endemic in tropical and subtropical regions worldwide, particularly in Thailand and northern Australia.[3] It was reported in 2008 that there had been an expansion of the affected regions due to significant natural disasters, and it could be found in Southern China, Hong Kong, and countries in America.[4] B. pseudomallei, amongst other pathogens, has been found in monkeys imported into the United States from Asia for laboratory use, posing a risk that the pathogen could be introduced into the country.[5]
Although it is mainly a soil-dwelling bacteria, a study performed by Apinya Pumpuang and others showed that Burkholderia pseudomallei survived in distilled water for 16 years, demonstrating that it is capable of living in water if a specific environment is provided.[6] It is resistant to a variety of harsh conditions including nutrient deficiency, extreme temperature or pH.[7] It infects humans, causing the disease melioidosis;[8] mortality is 20–50% even with treatment. The CDC classifies it as a "Tier 1 select agent" with potential as a bioterrorism agent.[5] It infects other animals, most commonly livestock such as goats, pigs, and sheep, less frequently.[9] It is also capable of infecting plants in a laboratory setting.[10]
Burkholderia pseudomallei measures 2–5 μm in length and 0.4–0.8 μm in diameter and is capable of self-propulsion using flagella. The bacteria can grow in a number of artificial nutrient environments, especially betaine- and arginine-containing ones.
In vitro, optimal proliferation temperature is reported around 40 °C in neutral or slightly acidic environments (pH 6.8–7.0). The majority of strains are capable of oxidation, not fermentation, of sugars without gas formation (most importantly, glucose and galactose; older cultures are reported to also metabolize maltose and starch). Bacteria produce both exo- and endotoxins. The role of the toxins identified in the process of melioidosis symptom development has not been fully elucidated.[11]
Identification
Burkholderia pseudomallei is not fastidious and grows on a large variety of culture media (blood agar, MacConkey agar, EMB, etc.). Ashdown's medium (or Burkholderia cepacia medium) may be used for selective isolation.[12] Cultures typically become positive in 24 to 48 hours (this rapid growth rate differentiates the organism from B. mallei, which typically takes a minimum of 72 hours to grow). Colonies are wrinkled, have a metallic appearance, and possess an earthy odor. On Gram staining, the organism is a Gram-negative rod with a characteristic "safety pin" appearance (bipolar staining). On sensitivity testing, the organism appears highly resistant (it is innately resistant to many antibiotics including colistin and gentamicin) and that again differentiates it from B. mallei, which is in contrast, exquisitely sensitive to many antibiotics. For environmental specimens only, differentiation from the nonpathogenic B. thailandensis using an arabinose test is necessary (B. thailandensis is never isolated from clinical specimens).[13] The laboratory identification of B. pseudomallei has been described in the literature.[14]
The classic textbook description of B. pseudomallei in clinical samples is of an intracellular, bipolar-staining, Gram-negative rod, but this is of little value in identifying the organism from clinical samples.[14] Some[15] suggest the Wayson stain is useful for this purpose, but this has been shown not to be the case.[16]
Laboratory identification of B. pseudomallei can be difficult, especially in Western countries where it is rarely seen. The large, wrinkled colonies look like environmental contaminants, so are often discarded as being of no clinical significance. Colony morphology is very variable and a single strain may display multiple colony types,[17][18] so inexperienced laboratory staff may mistakenly believe the growth is not pure. The organism grows more slowly than other bacteria that may be present in clinical specimens, and in specimens from nonsterile sites, is easily overgrown. Nonsterile specimens should, therefore, be cultured in selective media (e.g., Ashdown's[19][20] or B. cepacia medium).[12] For heavily contaminated samples, such as feces, a modified version of Ashdown's that includes norfloxacin, amoxicillin, and polymyxin B has been proposed.[21] In blood culture, the BacT/ALERT MB system (normally used for culturing mycobacteria) by bioMérieux has been shown to have superior yields compared to conventional blood culture media.[22]
Even when the isolate is recognized to be significant, commonly used identification systems may misidentify the organism as Chromobacterium violaceum or other nonfermenting, Gram-negative bacilli such as Burkholderia cepacia or Pseudomonas aeruginosa.[23][24] Again, because the disease is rarely seen in Western countries, identification of B. pseudomallei in cultures may not actually trigger alarms in physicians unfamiliar with the disease.[25] Routine biochemical methods for identification of bacteria vary widely in their identification of this organism: the API 20NE system accurately identifies B. pseudomallei in 99% of cases,[26] as does the automated Vitek 1 system, but the automated Vitek 2 system only identifies 19% of isolates.[24]
The pattern of resistance to antimicrobials is distinctive, and helps to differentiate the organism from P. aeruginosa. The majority of B. pseudomallei isolates are intrinsically resistant to all aminoglycosides (via an efflux pump mechanism),[27] but sensitive to co-amoxiclav:[28] this pattern of resistance almost never occurs in P. aeruginosa and is helpful in identification.[29] Unfortunately, the majority of strains in Sarawak, Borneo, are susceptible to aminoglycosides and macrolides, which means the conventional recommendations for isolation and identification do not apply there.[30]
Molecular methods (PCR) of diagnosis are possible, but not routinely available for clinical diagnosis.[31][32] Fluorescence in situ hybridisation has also been described, but has not been clinically validated, and it is not commercially available.[33] In Thailand, a latex agglutination assay is widely used,[26] while a rapid immunofluorescence technique is also available in a small number of centres.[34]
Characteristics of Burkholderia pseudomallei
Morphological, physiological, and biochemical characteristics of Burkholderia pseudomallei are shown in the Table below.
| Test type | Test | Characteristics |
| Colony characters | Size | 2–5 μm in length and 0.4–0.8 μm in diameter |
| Type | Round | |
| Color | Whitish | |
| Shape | Multiple | |
| Morphological characters | Shape | Rod (Variable) |
| Physiological characters | Motility | + |
| Growth at 6.5% NaCl | + | |
| Biochemical characters | Gram staining | - |
| Oxidase | + | |
| Catalase | +[35] | |
| Oxidative-Fermentative | ||
| Motility | + | |
| Methyl Red | ||
| Voges-Proskauer | ||
| Indole | -[36] | |
| H2S Production | - | |
| Urease | ||
| Nitrate reductase | + | |
| β-Galactosidase | ||
| Hydrolysis of | Gelatin | + |
| Casein | ||
| Utilization of | Glycerol | + |
| Galactose | + | |
| D-Glucose | + | |
| D-Fructose | + | |
| D-Mannose | + | |
| Mannitol | Variable |
Note: + = Positive, – =Negative
Disinfection
Burkholderia pseudomallei is susceptible to numerous disinfectants, including benzalkonium chloride, iodine, mercuric chloride, potassium permanganate, 1% sodium hypochlorite, 70% ethanol, 2% glutaraldehyde, and to a lesser extent, phenolic preparations.[37] B. pseudomallei is effectively killed by the commercial disinfectants, Perasafe and Virkon.[38] The microorganism can also be destroyed by heating to above 74 °C for 10 min or by ultraviolet irradiation.[39]
Clinical importance
Burkholderia pseudomallei infection in humans is called melioidosis or Whitmore’s disease. It is spread though direct contact with water or soil that holds the bacteria. There have been few cases of transmission of the bacteria perinatally.[40] Its mortality is 20 to 50% even with treatment.[28]
Treatment
The antibiotic of choice is ceftazidime.[28] While various antibiotics are active in vitro (e.g., chloramphenicol, doxycycline, co-trimoxazole), they have been proven to be inferior in vivo for the treatment of acute melioidosis.[41] Disc diffusion tests are unreliable when looking for co-trimoxazole resistance in B. pseudomallei (they greatly overestimate resistance) and Etests or agar dilution tests should be used in preference.[42][43] The actions of co-trimoxazole and doxycycline are antagonistic, which suggests these two drugs ought not to be used together.[44]
The organism is intrinsically resistant to gentamicin[45] and colistin, and this fact is helpful in the identification of the organism.[46] Kanamycin is used to kill B. pseudomallei in the laboratory, but the concentrations used are much higher than those achievable in humans.[47]
Pathogenicity mechanisms and virulence factors
Burkholderia pseudomallei is an opportunistic pathogen. An environmental organism, it has no requirement to pass through an animal host to replicate. From the point of view of the bacterium, human infection is a developmental "dead end".[48]
Strains which cause disease in humans differ from those causing disease in other animals, by possessing certain genomic islands.[49] It may have the ability to cause disease in humans because of DNA it has acquired from other microorganisms.[49] Its mutation rate is also high, and the organism continues to evolve even after infecting a host.[50]
Burkholderia pseudomallei is able to invade cells (it is an intracellular pathogen).[51] It is able to polymerise actin, and to spread from cell to cell, causing cell fusion and the formation of multinucleated giant cells.[52] It possesses a uniquely fusogenic type VI secretion system that is required for cell-cell spread and virulence in mammalian hosts.[53] The bacterium also expresses a toxin called lethal factor 1.[54] B. pseudomallei is one of the first Proteobacteria to be identified as containing an active type VI secretion system. It is also the only organism identified that contains up to six different type VI secretion systems.[55]
B. pseudomallei is intrinsically resistant to many antimicrobial agents by virtue of its efflux pump mechanism. This mediates resistance to aminoglycosides (AmrAB-OprA), tetracyclines, fluoroquinolones, and macrolides (BpeAB-OprB).[56]
Vaccine candidates
As of 2021 no vaccine had been licensed, although many had been evaluated in pre-clinical studies.[57]
Vaccine candidates have been suggested. Aspartate-β-semialdehyde dehydrogenase (asd) gene deletion mutants are auxotrophic for diaminopimelate (DAP) in rich media and auxotrophic for DAP, lysine, methionine and threonine in minimal media.[58] The Δasd bacterium (bacterium with the asd gene removed) protects against inhalational melioidosis in mice.[59]
Transformation
Burkholderia pseudomoallei can go through transformation. The bacteria is able to uptake a free plasmid using electroporation and the plasmid material will integrate into the host DNA when they are electrocompetent. An example is given by an experiment performed by Mack K. and Titball R. W., which showed that a Burkholderia pseudomallei 4845 was capable of transformation by electroporation, utilizing the incQ plasmid pKT230.[60]
References
- ↑ Yabuuchi, E; Kosako, Y; Oyaizu, H; Yano, I; Hotta, H; Hashimoto, Y; Ezaki, T; Arakawa, M (1992). "Proposal of Burkholderia gen. nov. and transfer of seven species of the genus Pseudomonas homology group II to the new genus, with the type species Burkholderia cepacia (Palleroni and Holmes 1981) comb. nov". Microbiol Immunol. 36 (12): 1251–75. doi:10.1111/j.1348-0421.1992.tb02129.x. PMID 1283774.
- ↑ "Burkholderia pseudomallei". VirginiaTech Pathogen Database. Archived from the original on 2006-09-01. Retrieved 2006-03-26.
- ↑ Limmathurotsakul, Direk; Golding, Nick; Dance, David A. B.; Messina, Jane P.; Pigott, David M.; Moyes, Catherine L.; Rolim, Dionne B.; Bertherat, Eric; Day, Nicholas P. J. (2016-01-11). "Predicted global distribution of Burkholderia pseudomallei and burden of melioidosis". Nature Microbiology. 1 (1): 15008. doi:10.1038/nmicrobiol.2015.8. ISSN 2058-5276. PMC 4746747. PMID 26877885.
- ↑ Currie, Bart J.; Dance, David A.B.; Cheng, Allen C. (December 2008). "The global distribution of Burkholderia pseudomallei and melioidosis: an update". Transactions of the Royal Society of Tropical Medicine and Hygiene. 102: S1 – S4. doi:10.1016/S0035-9203(08)70002-6. PMID 19121666. Archived from the original on 2022-06-20. Retrieved 2023-06-09.
- ↑ 5.0 5.1 Colley, Claire (18 December 2022). "US public not warned that monkeys imported from Cambodia carried deadly pathogens". The Guardian. Archived from the original on 31 March 2023. Retrieved 9 June 2023.
- ↑ Pumpuang, Apinya; Chantratita, Narisara; Wikraiphat, Chanthiwa; Saiprom, Natnaree; Day, Nicholas P.J.; Peacock, Sharon J.; Wuthiekanun, Vanaporn (October 2011). "Survival of Burkholderia pseudomallei in distilled water for 16 years". Transactions of the Royal Society of Tropical Medicine and Hygiene. 105 (10): 598–600. doi:10.1016/j.trstmh.2011.06.004. ISSN 0035-9203. PMC 3183224. PMID 21764093. Archived from the original on 2023-06-30. Retrieved 2023-06-09.
- ↑ Cheng, Allen C.; Currie, Bart J. (April 2005). "Melioidosis: Epidemiology, Pathophysiology, and Management". Clinical Microbiology Reviews. 18 (2): 383–416. doi:10.1128/CMR.18.2.383-416.2005. ISSN 0893-8512. PMC 1082802. PMID 15831829.
- ↑ "Melioidosis". CDC. 2022-07-27. Archived from the original on 2011-06-18. Retrieved 2023-06-09.
- ↑ "Melioidosis". New Jersey Department of Agriculture. 2003. Archived from the original on 2008-05-18. Retrieved 2023-06-09.
- ↑ Lee YH, Chen Y, Ouyang X, Gan YH (2010). "Identification of tomato plant as a novel host model for Burkholderia pseudomallei". BMC Microbiol. 10: 28. doi:10.1186/1471-2180-10-28. PMC 2823722. PMID 20109238.
{{cite journal}}: CS1 maint: unflagged free DOI (link) - ↑ Haase A, Janzen J, Barrett S, Currie B (July 1997). "Toxin production by Burkholderia pseudomallei strains and correlation with severity of melioidosis". Journal of Medical Microbiology. 46 (7): 557–63. doi:10.1099/00222615-46-7-557. PMID 9236739.
- ↑ 12.0 12.1 Peacock SJ, Chieng G, Cheng AC, et al. (October 2005). "Comparison of Ashdown's medium, Burkholderia cepacia medium, and Burkholderia pseudomallei selective agar for clinical isolation of Burkholderia pseudomallei". Journal of Clinical Microbiology. 43 (10): 5359–61. doi:10.1128/JCM.43.10.5359-5361.2005. PMC 1248505. PMID 16208018.
- ↑ Chaiyaroj SC, Kotrnon K, Koonpaew S, Anantagool N, White NJ, Sirisinha S (1999). "Differences in genomic macrorestriction patterns of arabinose-positive (Burkholderia thailandensis) and arabinose-negative Burkholderia pseudomallei". Microbiology and Immunology. 43 (7): 625–30. doi:10.1111/j.1348-0421.1999.tb02449.x. PMID 10529102.
- ↑ 14.0 14.1 Walsh AL, Wuthiekanun V (1996). "The laboratory diagnosis of melioidosis". Br J Biomed Sci. 53 (4): 249–53. PMID 9069100.
- ↑ Brundage WG, Thuss CJ, Walden DC (March 1968). "Four fatal cases of melioidosis in U. S. soldiers in Vietnam. Bacteriologic and pathologic characteristics". The American Journal of Tropical Medicine and Hygiene. 17 (2): 183–91. doi:10.4269/ajtmh.1968.17.183. PMID 4869109.
- ↑ Sheridan EA, Ramsay AR, Short JM, Stepniewska K, Wuthiekanun V, Simpson AJ (May 2007). "Evaluation of the Wayson stain for the rapid diagnosis of melioidosis". Journal of Clinical Microbiology. 45 (5): 1669–70. doi:10.1128/JCM.00396-07. PMC 1865910. PMID 17360835.
- ↑ Chantratita N, Wuthiekanun V, Boonbumrung K, et al. (2007). "Biological relevance of colony morphology and phenotypic switching by Burkholderia pseudomallei.". J Bacteriol. 189 (3): 807–17. doi:10.1128/JB.01258-06. PMC 1797308. PMID 17114252.
- ↑ Pumpuang A, Chantratita N, Wikraiphat C, et al. (2011). "Survival of Burkholderia pseudomallei in distilled water for 16 years". Trans R Soc Trop Med Hyg. 105 (10–2): 598–600. doi:10.1016/j.trstmh.2011.06.004. PMC 3183224. PMID 21764093.
- ↑ Ashdown LR (1979). "An improved screening technique for isolation of Pseudomonas pseudomallei from clinical specimens". Pathology. 11 (2): 293–7. doi:10.3109/00313027909061954. PMID 460953.
- ↑ Roesnita B; Tay ST; Puthucheary SD; Sam IC. (2012). "Diagnostic use of Burkholderia pseudomallei selective media in a low prevalence setting". Trans R Soc Trop Med Hyg. 106 (2): 131–3. doi:10.1016/j.trstmh.2011.10.007. PMID 22112687.
- ↑ Goodyear A, Strange L, Rholl DA, et al. (2013). "An improved selective culture medium enhances the isolation of Burkholderia pseudomallei from contaminated specimens". Am J Trop Med Hyg. 89 (5): 973–82. doi:10.4269/ajtmh.13-0119. PMC 3820346. PMID 24062483.
- ↑ Jorakate P, Higdon M, Kaewpan A, et al. (2015). "Contribution of the BacT/ALERT MB Mycobacteria Bottle to bloodstream infection surveillance in Thailand: added yield for Burkholderia pseudomallei.". J Clin Microbiol. 53 (3): 910–4. doi:10.1128/JCM.02008-14. PMC 4390673. PMID 25588650.
- ↑ Inglis TJ, Chiang D, Lee GS, Chor-Kiang L (February 1998). "Potential misidentification of Burkholderia pseudomallei by API 20NE". Pathology. 30 (1): 62–4. doi:10.1080/00313029800169685. PMID 9534210. S2CID 31987728.
- ↑ 24.0 24.1 Lowe P, Engler C, Norton R (December 2002). "Comparison of automated and nonautomated systems for identification of Burkholderia pseudomallei". Journal of Clinical Microbiology. 40 (12): 4625–7. doi:10.1128/JCM.40.12.4625-4627.2002. PMC 154629. PMID 12454163.
- ↑ Kite-Powell A, Livengood JR, Suarez J, et al. (2006). "Imported Melioidosis—South Florida, 2005". Morb Mortal Wkly Rep. 55 (32): 873–6. PMID 16915220. Archived from the original on 2023-04-24. Retrieved 2023-06-09.
- ↑ 26.0 26.1 Amornchai P, Chierakul W, Wuthiekanun V, et al. (November 2007). "Accuracy of Burkholderia pseudomallei identification using the API 20NE system and a latex agglutination test". Journal of Clinical Microbiology. 45 (11): 3774–6. doi:10.1128/JCM.00935-07. PMC 2168515. PMID 17804660.
- ↑ Moore RA, DeShazer D, Reckseidler S, Weissman A, Woods DE (March 1999). "Efflux-mediated aminoglycoside and macrolide resistance in Burkholderia pseudomallei". Antimicrobial Agents and Chemotherapy. 43 (3): 465–70. doi:10.1128/AAC.43.3.465. PMC 89145. PMID 10049252.
- ↑ 28.0 28.1 28.2 Wuthiekanun V, Peacock SJ (June 2006). "Management of melioidosis". Expert Review of Anti-infective Therapy. 4 (3): 445–55. doi:10.1586/14787210.4.3.445. PMID 16771621. S2CID 35619761.
- ↑ Hodgson K, Engler C, Govan B, et al. (2009). "A comparison of routine bench and molecular diagnostic methods in the identification of Burkholderia pseudomallei". J Clin Microbiol. 47 (5): 1578–80. doi:10.1128/JCM.02507-08. PMC 2681847. PMID 19279182.
- ↑ Podin Y, Sarovich DS, Price EP, Kaestli M, Mayo M, Hii K, et al. (2013). "Burkholderia pseudomallei from Sarawak, Malaysian Borneo are predominantly susceptible to aminoglycosides and macrolides". Antimicrob Agents Chemother. 58 (1): 162–6. doi:10.1128/AAC.01842-13. PMC 3910780. PMID 24145517.
- ↑ Ruppitsch W, Stöger A, Indra A, et al. (March 2007). "Suitability of partial 16S ribosomal RNA gene sequence analysis for the identification of dangerous bacterial pathogens". Journal of Applied Microbiology. 102 (3): 852–9. doi:10.1111/j.1365-2672.2006.03107.x. PMID 17309636.
- ↑ Wattiau P, Van Hessche M, Neubauer H, Zachariah R, Wernery U, Imberechts H (March 2007). "Identification of Burkholderia pseudomallei and related bacteria by multiple-locus sequence typing-derived PCR and real-time PCR". Journal of Clinical Microbiology. 45 (3): 1045–8. doi:10.1128/JCM.02350-06. PMC 1829090. PMID 17251403.
- ↑ Hagen RM, Frickmann H, Elschner M, et al. (2011). "Rapid identification of Burkholderia pseudomallei and Burkholderia mallei by fluorescence in situ hybridization (FISH) from culture and paraffin-embedded tissue samples". International Journal of Medical Microbiology. 301 (7): 585–90. doi:10.1016/j.ijmm.2011.04.017. PMID 21658996.
- ↑ Wuthiekanun V, Desakorn V, Wongsuvan G, et al. (April 2005). "Rapid immunofluorescence microscopy for diagnosis of melioidosis". Clinical and Diagnostic Laboratory Immunology. 12 (4): 555–6. doi:10.1128/CDLI.12.4.555-556.2005. PMC 1074392. PMID 15817767.
- ↑ "Burkholderia Pseudomallei". www.antimicrobe.org. Archived from the original on 2017-05-10. Retrieved 2022-04-21.
- ↑ Hemarajata, Peera; Baghdadi, Jonathan D.; Hoffman, Risa; Humphries, Romney M. (December 2016). "Burkholderia pseudomallei: Challenges for the Clinical Microbiology Laboratory". Journal of Clinical Microbiology. 54 (12): 2866–2873. doi:10.1128/JCM.01636-16. ISSN 0095-1137. PMC 5121373. PMID 27654336.
- ↑ Miller, WR; Pannell, L; Cravitz, L; Tanner, WA; Ingalls, MS (1948). "Studies on certain biological characteristics of Malleomyces mallei and Malleomyces pseudomallei: I. Morphology, cultivation, viability, and isolation from contaminated specimens". J Bacteriol. 55 (1): 115–126. doi:10.1128/JB.55.1.115-126.1948. PMC 518415. PMID 16561426.
- ↑ Wuthiekanun V, Wongsuwan G, Pangmee S, Teerawattanasook N, Day NP, Peacock SJ (2010). "Perasafe, Virkon and bleach are bactericidal for Burkholderia pseudomallei, a select agent and the cause of melioidosis". J Hosp Infect. 77 (2): 183–4. doi:10.1016/j.jhin.2010.06.026. PMC 3036794. PMID 20832143.
- ↑ Rose, L. J.; O'Connell, H. (2009-05-01). "UV Light Inactivation of Bacterial Biothreat Agents". Applied and Environmental Microbiology. 75 (9): 2987–2990. Bibcode:2009ApEnM..75.2987R. doi:10.1128/AEM.02180-08. ISSN 0099-2240. PMC 2681683. PMID 19270145.
- ↑ Rodríguez, José Y.; Huertas, Mónica G.; Rodríguez, Gerson J.; Vargas-Otalora, Sandra; Benıtez-Peñuela, Miguel A.; Esquea, Kelin; Rios, Rafael; Mendoza, Laura R.; Diaz, Lorena; Reyes, Jinnethe; Álvarez-Moreno, Carlos A. (2020-11-04). "Case Report: Gestational Melioidosis through Perinatal Transmission". The American Journal of Tropical Medicine and Hygiene. 103 (5): 1838–1840. doi:10.4269/ajtmh.20-0223. ISSN 0002-9637. PMC 7646751. PMID 32748772.
- ↑ White NJ, Dance DA, Chaowagul W, Wattanagoon Y, Wuthiekanun V, Pitakwatchara N (September 1989). "Halving of mortality of severe melioidosis by ceftazidime". Lancet. 2 (8665): 697–701. doi:10.1016/S0140-6736(89)90768-X. PMID 2570956. S2CID 28919574.
- ↑ Lumbiganon P, Tattawasatra U, Chetchotisakd P, et al. (2000). "Comparison between the antimicrobial susceptibility of Burkholderia pseudomallei to trimethoprim-sulfamethoxazole by standard disk diffusion method and by minimal inhibitory concentration determination". J Med Assoc Thai. 83 (8): 856–60. PMID 10998837.
- ↑ Wuthiekanun V, Cheng AC, Chierakul W, et al. (2005). "Trimethoprim/sulfamethoxazole resistance in clinical isolates of Burkholderia pseudomallei". J Antimicrob Chemother. 55 (6): 1029–31. doi:10.1093/jac/dki151. PMID 15886263.
- ↑ Saraya S, Soontornpas C, Chindavijak B, Mootsikapun P (2009). "In vitro interactions between cotrimoxazole and doxycycline in Burkholderia pseudomallei: how important is this combination in maintenance therapy of melioidosis?". Indian J Med Microbiol. 27 (1): 88–9. doi:10.1016/S0255-0857(21)01773-4. PMID 19172079.
- ↑ Trunck LA; Propst, KL; Wuthiekanun, V; Tuanyok, A; Beckstrom-Sternberg, SM; Beckstrom-Sternberg, JS; Peacock, SJ; Keim, P; et al. (2009). Picardeau, Mathieu (ed.). "Molecular basis of rare aminoglycoside susceptibility and pathogenesis of Burkholderia pseudomallei clinical isolates from Thailand". PLOS Negl Trop Dis. 3 (9): e519. doi:10.1371/journal.pntd.0000519. PMC 2737630. PMID 19771149.
{{cite journal}}: CS1 maint: unflagged free DOI (link) - ↑ Ashdown, LR (1979). "Identification of Pseudomonas pseudomallei in the clinical laboratory". J Clin Pathol. 32 (5): 500–4. doi:10.1136/jcp.32.5.500. PMC 1145715. PMID 381328.
- ↑ Kespichayawattana W, Intachote P, Utaisincharoen P, Stitaya Sirisinha S (2004). "Virulent Burkholderia pseudomallei is more efficient than avirulent Burkholderia thailandensis in invasion of and adherence to cultured human epithelial cells". Microbial Pathogenesis. 36 (5): 287–9. doi:10.1016/j.micpath.2004.01.001. PMID 15043863.
- ↑ Nandi T, Ong C, Singh AP, Boddey J, Atkins T, Sarkar-Tyson M, Essex-Lopresti AE, Chua HH, Pearson T, Kreisberg JF, Nilsson C, Ariyaratne P, Ronning C, Losada L, Ruan Y, Sung WK, Woods D, Titball RW, Beacham I, Peak I, Keim P, Nierman WC, Tan P (2010). Guttman DS (ed.). "A genomic survey of positive selection in Burkholderia pseudomallei provides insights into the evolution of accidental virulence". PLOS Pathog. 6 (4): e1000845. doi:10.1371/journal.ppat.1000845. PMC 2848565. PMID 20368977.
{{cite journal}}: CS1 maint: unflagged free DOI (link) - ↑ 49.0 49.1 Sim SH, Yu Y, Lin CH, et al. (October 2008). Achtman M (ed.). "The core and accessory genomes of Burkholderia pseudomallei: implications for human melioidosis". PLOS Pathog. 4 (10): e1000178. doi:10.1371/journal.ppat.1000178. PMC 2564834. PMID 18927621.
{{cite journal}}: CS1 maint: unflagged free DOI (link) - ↑ Price EP, Hornstra HM, Limmathurotsakul D, et al. (2010). Guttman DS (ed.). "Within-host evolution of Burkholderia pseudomallei in four cases of acute melioidosis". PLOS Pathog. 6 (1): e1000725. doi:10.1371/journal.ppat.1000725. PMC 2799673. PMID 20090837.
{{cite journal}}: CS1 maint: unflagged free DOI (link) - ↑ Wiersinga WJ, van der Poll T, White NJ, Day NP, Peacock SJ (2006). "Melioidosis: insights into the pathogenicity of Burkholderia pseudomallei". Nature Reviews Microbiology. 4 (4): 272–82. doi:10.1038/nrmicro1385. PMID 16541135. S2CID 23909148.
- ↑ Kespichayawattana W, Rattanachetkul S, Wanun T, et al. (2000). "Burkholderia pseudomallei induces cell fusion and actin-associated membrane protrusion: a possible mechanism for cell-to-cell spreading". Infect. Immun. 68 (9): 5377–84. doi:10.1128/IAI.68.9.5377-5384.2000. PMC 101801. PMID 10948167.
- ↑ Toesca, Isabelle J.; French, Christopher T.; Miller, Jeff F. (2014-04-01). "The Type VI secretion system spike protein VgrG5 mediates membrane fusion during intercellular spread by pseudomallei group Burkholderia species". Infection and Immunity. 82 (4): 1436–1444. doi:10.1128/IAI.01367-13. ISSN 1098-5522. PMC 3993413. PMID 24421040.
- ↑ Cruz-Migoni A, Hautbergue GM, Artymiuk PJ, et al. (2011). "A Burkholderia pseudomallei toxin inhibits helicase activity of translation factor eIF4A". Science. 334 (6057): 821–4. Bibcode:2011Sci...334..821C. doi:10.1126/science.1211915. PMC 3364511. PMID 22076380.
- ↑ Shalom G, Shaw JG, Thomas MS (August 2007). "In vivo expression technology identifies a type VI secretion system locus in Burkholderia pseudomallei that is induced upon invasion of macrophages". Microbiology. 153 (Pt 8): 2689–99. doi:10.1099/mic.0.2007/006585-0. PMID 17660433.
- ↑ Mima T, Schweizer HP (2010). "The BpeAB-OprB efflux pump of Burkholderia pseudomallei 1026b does not play a role in quorum sensing, virulence factor production, or extrusion of aminoglycosides, but is a broad-spectrum drug efflux system". Antimicrob. Agents Chemother. 54 (8): 3113–20. doi:10.1128/AAC.01803-09. PMC 2916348. PMID 20498323.
- ↑ Baker, Sarah M.; Settles, Erik W.; Davitt, Christopher; Gellings, Patrick; Kikendall, Nicole; Hoffmann, Joseph; Wang, Yihui; Bitoun, Jacob; Lodrigue, Kasi-Russell; Sahl, Jason W.; Keim, Paul; Roy, Chad; McLachlan, James; Morici, Lisa A. (29 January 2021). "Burkholderia pseudomallei OMVs derived from infection mimicking conditions elicit similar protection to a live-attenuated vaccine". NPJ Vaccines. 6 (1): 18. doi:10.1038/s41541-021-00281-z. ISSN 2059-0105. PMC 7846723. PMID 33514749.
- ↑ Norris MH, Kang Y, Lu D, Wilcox BA, Hoang TT (2009). "Glyphosate resistance as a novel select-agent-compliant, non-antibiotic-selectable marker in chromosomal mutagenesis of the essential genes asd and dapB of Burkholderia pseudomallei.". Appl Environ Microbiol. 75 (19): 6062–75. Bibcode:2009ApEnM..75.6062N. doi:10.1128/AEM.00820-09. PMC 2753064. PMID 19648360.
- ↑ Norris MH, Propst KL, Kang Y, et al. (2011). "The Burkholderia pseudomallei Δasd mutant exhibits attenuated intracellular infectivity and imparts protection against acute inhalation melioidosis in mice". Infect Immun. 79 (10): 4010–8. doi:10.1128/IAI.05044-11. PMC 3187240. PMID 21807903.
- ↑ Mack, K.; Titball, R. W. (1996-11-01). "Transformation of Burkholderia pseudomallei by electroporation". Analytical Biochemistry. 242 (1): 73–76. doi:10.1006/abio.1996.0430. ISSN 0003-2697. PMID 8923967. Archived from the original on 2023-02-18. Retrieved 2023-06-09.
External links
- "Burkholderia pseudomallei genomes and related information". PATRIC. NIAID. Archived from the original on 2011-08-24. Retrieved 2010-06-24.
- "Getting a Grip on the Great Mimicker: Secrets of a Stealth Organism". Wellcome Trust. Archived from the original on 2009-09-27. Retrieved 2006-03-27.
- Pathema Burkholderia resource
- "Burkholderia pseudomallei". NCBI Taxonomy Browser. 28450. Archived from the original on 2020-11-11. Retrieved 2023-06-09.